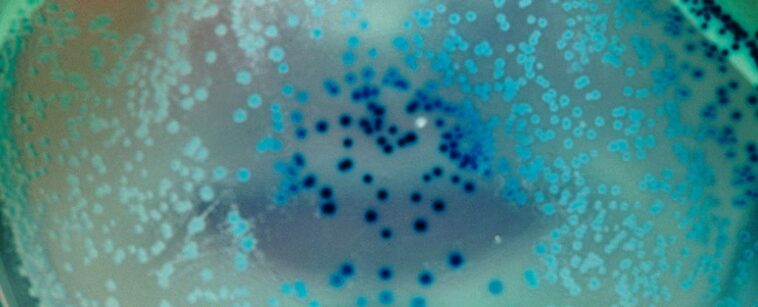

Според ново изследване едноклетъчен организъм без мозък или нервна система може да формира спомени и да ги предава на бъдещите поколения.
Вездесъщата бактерия Escherichia coli е една от най-изследваните форми на живот на Земята и въпреки това учените продължават да откриват неочаквани начини, по които тя оцелява и се разпространява.
Изследователи от Тексаския университет и Университета на Делауеър сега са открили потенциална система за памет, която позволява на E. coli да „помни“ минали преживявания в продължение на няколко часа и поколения след това.
Екипът твърди, че доколкото им е известно, този вид бактериална памет не е откриван досега.
Очевидно е, че паметта, която учените обсъждат в този случай, не е същата като съзнателната човешка памет.
Вместо това феноменът на бактериалната памет описва как информацията от минали преживявания влияе върху вземането на настоящи решения.
„Бактериите нямат мозък, но могат да събират информация от околната среда и ако са се сблъсквали често с нея, могат да съхраняват тази информация и да имат бърз достъп до нея по-късно в своя полза“, обяснява водещият изследовател молекулярният биолог Сувик Бхатачария от UT.
Констатациите на Бхатачария и екипа му се основават на силни асоциации от повече от 10 000 бактериални „роеви“ опити.
При тези експерименти се проверява дали клетките на E. coli върху една плака ще се роят заедно в една мигрираща маса, която се движи с един и същ двигател. Подобно поведение обикновено показва, че клетките се обединяват, за да търсят ефективно подходяща среда.
От друга страна, когато клетките на E. coli се струпват в лепкав биофилм, това е техният начин да колонизират хранителна повърхност.
При първоначалните експерименти изследователите излагат клетките на E. coli на няколко различни фактора на околната среда, за да видят кои условия предизвикват най-бързо роене.
В крайна сметка екипът установява, че вътреклетъчното желязо е най-силният предсказващ фактор за това дали бактериите се движат или остават.
Ниските нива на желязото са свързани с по-бързо и по-ефективно роене, докато по-високите нива водят до по-улегнал начин на живот.
Бактериален рояк

Сред клетките на E. coli от първо поколение това изглеждаше интуитивен отговор. Но след като са преживели само едно роене, клетките, които са имали ниски нива на желязо на по-късен етап от живота си, са били още по-бързи и по-ефективни в роенето, отколкото преди.
Нещо повече, тази „желязна“ памет се предала на поне четири последователни поколения дъщерни клетки, които се образуват от разделянето на майчината клетка на две нови клетки.
До седмото поколение дъщерни клетки тази желязна памет се губи по естествен път – въпреки че може да бъде възстановена, ако учените я подсилят изкуствено.
Авторите на изследването все още не са идентифицирали молекулярния механизъм, който стои зад потенциалната система за памет или нейната унаследяемост, но силната връзка между вътреклетъчното желязо и роевото поведение между поколенията предполага, че е налице някакво ниво на устойчива обусловеност.
Макар да е известно, че епигенетиката играе роля в предаването на „запомнени“ биологични настройки през поколенията на E. coli чрез регулиране на настройките за „включване“ и „изключване“ на специфични гени, изследователите смятат, че кратката продължителност на наследствеността означава, че тук това не е основният механизъм.
Желязото е свързано с множество реакции на стрес при бактериите. Образуването на система за памет между поколенията около него има голям еволюционен смисъл.
Базираната на желязото система за памет може да помогне на E. coli да се адаптира към лоши условия на околната среда или към антибиотици.
Една-единствена клетка на E. coli може да се удвои в рамките на половин час, така че способността за предаване на такава памет на дъщерни клетки вероятно също е полезна в бавно променяща се среда.
„Преди да има кислород в земната атмосфера, ранният клетъчен живот е използвал желязо за много клетъчни процеси“, казва Бхатачария.
„Желязото е от решаващо значение не само за възникването на живота на Земята, но и за еволюцията на живота. Логично е клетките да го използват по този начин.“
„В крайна сметка“, заключава Бхатачария, „колкото повече знаем за поведението на бактериите, толкова по-лесно е да се борим с тях“.
Изследването е публикувано в PNAS.
Последно обновена на 24 ноември 2023, 10:44 от Иван Петров